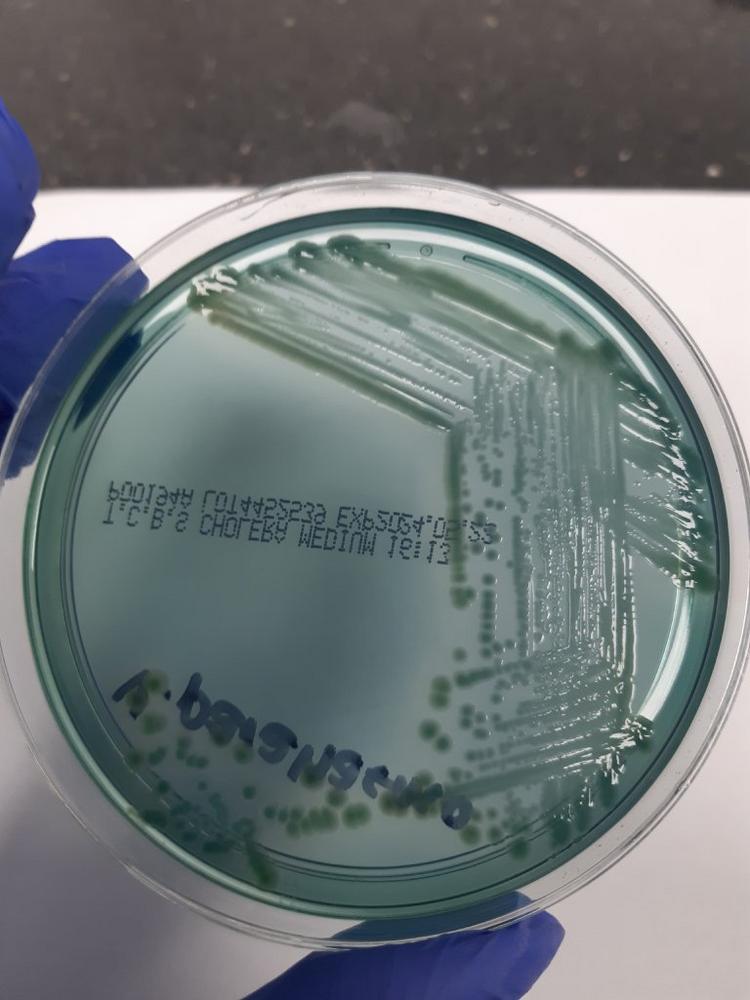

Rising Concerns
In recent years, there has been a noticeable increase in the number of gastrointestinal illness cases caused by Vibrio species. Several factors contribute to this rise:
- Global Warming: Increasing global temperatures have resulted in warmer waters, creating more favourable conditions for Vibrio to thrive.
- Demographic Changes: Population growth and an increase in tourism in coastal areas have led to higher exposure to contaminated waters.
- Recreational Water Use: More people are engaging in recreational activities in water, increasing the risk of illness.
- Seafood Consumption Patterns: Changes in seafood consumption habits have also contributed to the rise in Vibrio-related illnesses.
Our Response
As a result of these growing concerns, Precision Analysis — A Tentamus Company has seen an increase in requests for Vibrio testing in seafood. In response, we are proud to announce the expansion of our capabilities in Vibrio testing. Our enhanced services ensure the safety and quality of seafood, helping to protect public health.
With our advanced testing methods, Precision Analysis — A Tentamus Company can effectively detect and analyse Vibrio contamination, providing critical information to the seafood industry and consumers.
Tentamus Group GmbH
An der Industriebahn 26
13088 Berlin
Telefon: +49 (30) 206038-230
Telefax: +49 (30) 206038-190
http://www.tentamus.com
E-Mail: HelloUK@tentamus.com
![]()